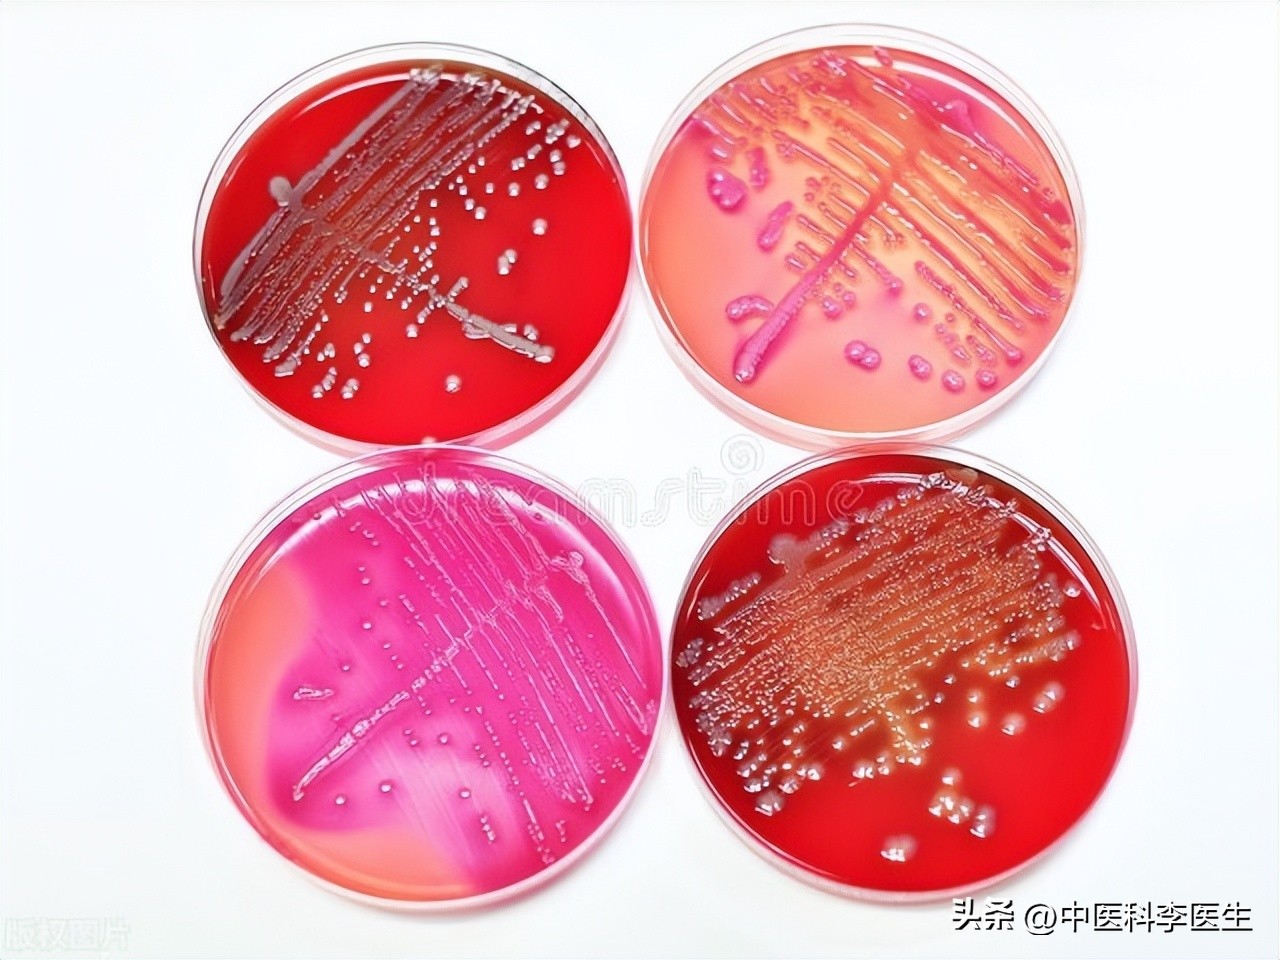
新冠二阳如何避免再感染,新冠二次阳了怎么吃药

新冠病毒问世已3年多,但在传染病学仍属于“三无产品”:无法追溯源头、无法找到中间宿主、至今无特效药和强效疫苗。加上新冠病毒变异快、逃逸本领多,国内感染人数总体上比较多,随着近期“二阳”升温,感染后如何用药再次引起关注。

新冠至今没有预防药物,只能是感染后用药,除了确诊后使用缓解症状药物,如退热药、止痛药、止泻药、镇咳药,还有抑制病情发展为重症的抗病毒药。有一类药物的使用争议较多,就是要不要用抗生素。
支持用的理由在于:去年底在“一阳”高峰期间,许多乡下老人感染后没有药,无奈之下村医用抗生素才挺过去。

反对的声音在于:新冠病毒属于RNA类病毒,抗生素打击的是细菌,病毒和细菌根本是两码事,乱用抗生素可能会引起严重问题。
从医生个人看:
如果仅仅是轻症患者,且没有出现新冠病毒合并细菌感染的情况,不需用抗生素,这就相当于一个人在沙漠渴得不行了,给他一个馒头,解决不了任何问题,可能还有新风险。

如果新冠患者确诊已继发细菌感染,通过血常规检查和临床常用感染标志物判断确认无误,根据医嘱选用抗生素,在医生指导下服用。
一句话:感染新冠后用抗生素,是满足条件才能用,否则就不要用,防止引起不良反应,甚至出现严重副作用。
其实,人体感染新冠病毒后,细菌也在蠢蠢欲动,由于新冠感染的路径是从呼吸道上皮组织开始,且攻击上皮组织引起损伤,无处不在的细菌就很容易造成炎症。如果人的免疫力较弱,被新冠病毒弄得阵脚大乱,会出现免疫系统紊乱,容易诱发细菌感染。

反映在症状上,就是抽血检查可见白细胞计数(WBC)、中粒细胞超过参考值,C反应蛋白(CRP)显著升高,大部分患者会出现黄痰、流黄涕、反复咳嗽或再次发热。不过,直接用“咳黄痰”来判断是不靠谱的,因为新冠病毒感染同样也能诱发这些症状,一定要通过检验指标确认。
如果只是普通咳嗽,咳白色痰液,可继续观察,视情用化痰止咳药,不必用抗生素。

如果到了要用抗生素的情形,该怎样用?
首先要明确新冠继发感染常见病菌有哪些,这是对症用药的基础。主要有:金黄色葡萄球菌、流感嗜血杆菌、活血性链球菌、肺炎链球菌、化脓性链球菌等,使用抗生素,也要对这些细菌敏感起效的才行。
首选的抗生素种类有口服青霉素类、第一至第三代头孢菌素类、呼吸喹诺酮类等。

1、阿莫西林克拉维酸钾,呼吸道细菌感染适用口服抗生素,属于复方抗生素,配比较突出,疗效较好,且副作用少。
2、头孢氨苄,属于第一代口服头孢菌素,适用于敏感细菌引起的呼吸道感染,但对流感嗜血杆菌作用差一些。
3、头孢丙烯,属于第二代口服头孢菌素,是一种广谱抗菌素,效果与头孢克洛相仿,且克服了头孢氨苄的缺点。
4、莫西沙星,是新一代氟喹诺酮类抗生素,口服后血药浓度高于其他药品,对呼吸类细菌引起的感染效果较好。

抗生素毕竟是药物,存在大小不等的副作用,如轻度过敏、皮疹、胃部不适、腹泻等,而且有用药禁忌,需严格遵医嘱和说明书使用,不可乱用、过量使用。
总之,新冠“二阳”用药,是否需要抗生素参与,一定要经过诊断,不能自行其是,防止出现问题。